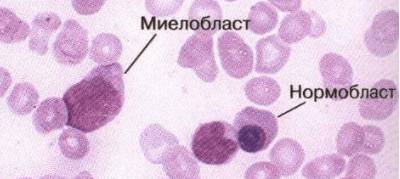

Содержание
Кровь — важнейшая трофическая ткань человеческого организма, которая обеспечивает все органы и ткани необходимыми питательными веществами, кислородом, служит буферным раствором , выполняет защитную и терморегуляционную функцию. У здорового человека кровь имеет постоянный состав , а малейшие изменения состава крови являются верным свидетельством заболевания. Кровь состоит из форменных элементов и плазмы (жидкого межклеточного вещества).
Что такое бластные клетки?

Являясь недозрелыми форменными элементами крови, нормобласты не способны в полной мере выполнять все функции, характерные для форменных элементов. Например, недозревшие эритроциты еще не лишились ядра , поэтому в их составе меньшего гемоглобина, чем у зрелого эритроцита.
Такая клетка может переносить меньше кислорода и углекислого газа.
Бласты в крови представляют собой незрелые клетки, которые обычно находятся в костном мозге и играют важную роль в образовании кровяных клеток. Врачи отмечают, что наличие бластов в периферической крови может указывать на различные заболевания, включая лейкемию и другие виды рака крови. В норме бласты составляют менее 5% от общего числа клеток в костном мозге, и их присутствие в крови может свидетельствовать о нарушении кроветворения. Специалисты подчеркивают важность своевременной диагностики и мониторинга состояния пациента, так как раннее выявление аномалий может существенно повлиять на эффективность лечения. Врачи рекомендуют проводить регулярные анализы крови, особенно для людей с предрасположенностью к заболеваниям крови.

Что такое острый лейкоз?
Одним из самых опасных заболеваний, при которых в крови повышается количество бластных клеток, является острый лейкоз.
Острый лейкоз — условное название, так как это заболевание никогда не переходит хронический лейкоз и наоборот, хронический лейкоз никогда не может перейти в острый. Острым лейкозом называются онкологическое поражение костного мозга, субстратом для которого как раз и являются бластные клетки.
Острый лейкоз сопровождается иммунодефицитными состояниями вследствие того, что красный костный мозг перестает производить лейкоциты в достаточном количестве. Организм поражается многочисленными инфекциями, что может привести к смерти.
Кроме того, характерное поражение стенок кровеносных сосудов и центральной нервной системы.
Посмотрите видео про острый лейкоз
https://youtube.com/watch?v=Ng0gmuN_1L8
Как определяется?
Небольшое количество этой ткани служит Сырьем для приготовления микропрепарата , который рассматривается с помощью обыкновенного светового микроскопа.
Внешний вид бластной клетки отличается от вида созревших форменных элементов, что позволяет специалисту легко различить несвойственный для крови здорового человека элемент среди прочих.
В зрительном поле микроскопа имеется специальная сетка, которая позволяет быстро подсчитать количество бластных клеток и количество нормальных форменных элементов крови. Затем полученное число умножается на объем крови и рассчитывается соотношение бластных клеток и нормальных форменных элементов.
На основании этих данных ставится диагноз.
Бласты в крови — это незрелые клетки, которые обычно присутствуют в костном мозге, но их наличие в периферической крови может указывать на различные заболевания. Многие люди, услышав о бластах, начинают паниковать, ведь это может быть признаком серьезных заболеваний, таких как лейкемия. Однако не всегда высокая концентрация бластов означает наличие рака. В некоторых случаях это может быть реакцией организма на инфекцию или стресс. Важно понимать, что для точной диагностики необходимо проводить дополнительные исследования и консультации с врачом. Люди часто делятся своими переживаниями и страхами, связанными с анализами крови, и важно поддерживать друг друга в такие моменты. Знание о бластах может помочь лучше понять свое здоровье и вовремя обратиться за медицинской помощью.

Подготовка к исследованию
Какой-либо специальной подготовки к анализу на бластные клетки крови не требуется. Анализ крови обычно берется с утра, пациенту противопоказано что-либо есть течение 8-12 часов перед забором крови. Кровь берут из вены. Перед анализом в течение нескольких дней требуется воздерживаться от приема спиртных напитков, минимум один день нельзя курить. Если пациент принимает лекарства, необходима консультация с врачом. Также на достоверность результатов могут оказать влияние различные инфекции, травмы, ожоги и отравление.
Все эти явления способствует повышению числа лейкоцитов, среди которых могут встречаться и недозревшие.
Нормы бластных телец
У здорового человека любого пола и возраста бластные клетки в крови отсутствуют.
Иными словами, для мужчин, женщин и детей норма бластных клеток будет одинакова – 0%.
В красном костном мозге наличествует до 1% таких клеток у здорового человека и до 10% у больного (например, простудой или гриппом), однако, на составе крови эти колебания обычно не отражаются.
Отклонения от нормы
Причины
Самой распространённой причиной появления бластных клеток в русле крови является острый лейкоз.
Чем больше этих элементов присутствует в плазме, тем более обширно поражение и тяжелее стадия заболевания.
Что происходит?
При лейкозе нормобласты неконтролируемо делятся и попадают в капилляры костного мозга в недозревшем состоянии, откуда поступают в другие кровеносные сосуды. Количество нормальных форменных элементов при этом снижается, что обусловливает появление симптомов лейкоза.
Что делать?
Прежде всего нужно установить, какой именно костный мозг повреждён. В организме человека красный костный мозг располагается в эпифизах (головках) трубчатых костей, например, бедренных, а так же в позвонках, костях таза и в грудине.
Для выявления очага заболевания применяют пункцию (забор небольшого количества клеток ткани для исследования под микроскопом). Когда будет установлено, где находится очаг заболевания, начинается длительный процесс лечения.
Вероятнее всего, пациенту придётся пересаживать здоровый костный мозг от другого человека.
Без хирургического вмешательства болезнь тоже можно вылечить. Для этого применяется химиотерапия. Специальные препараты, действие которых направлено против способных к делению клеток, токсичны для опухоли, но практически безвредны для здоровых дифференцированных клеток. При этом, однако, погибают и слабо дифференцированные, способные к делению клетки самого организма (клетки волосяных луковиц, эпителия кишечника и т.д.). Поэтому химиотерапия является изнуряющей и мучительной процедурой.
Вывод
Таким образом, бласты в крови это недозревшие форменные элементы, попавшие в кровяное русло при поражении костного мозга онкологическим заболеванием (острый лейкоз).
У здорового человека отсутствуют.
Выявляются путём исследования образца крови под микроскопом.
Вопрос-ответ
Что означает наличие бластов в крови?
Бласты – это быстро растущие клетки. Здоровая бластная клетка со временем развивается в какую-либо полезную клетку крови. В норме число бластов не превышает 1% от всех клеток костного мозга. В кровь они почти никогда не выходят.
Сколько бластов при лейкозе?
Повышенное количество лейкоцитов (более 10,0 — 10^9/л) определяется приблизительно у 1/2 больных, а более 50,0 — 10^9/л — у 1/5 пациентов. Абсолютным показателем заболевания является появление бластных клеток в периферической крови, доля которых в общем количестве лейкоцитов может варьировать (от 1—2 до 90% и более).
Что должно насторожить в общем анализе крови?
В общем анализе крови следует насторожиться при наличии аномальных значений, таких как низкий уровень гемоглобина (анемия), повышенное количество лейкоцитов (возможное воспаление или инфекция), низкий уровень тромбоцитов (риск кровотечений), а также отклонения в показателях СОЭ (скорости оседания эритроцитов), которые могут указывать на воспалительные процессы или другие заболевания.
Какой показатель в крови указывает на лейкоз?
Описание симптомов лейкоза. Для начальных стадий развития лейкоза характерно увеличение уровня лейкоцитов в крови до показателей 50 000/1 мм³. В некоторых случаях происходит увеличение метамиелоцитов и миелоцитов, также встречаются единичные выявления миелобластов и промиелоцитов.
Советы
СОВЕТ №1
Изучите основные функции бластов в организме. Бласты — это незрелые клетки, которые играют важную роль в образовании крови. Понимание их функции поможет вам лучше осознать, почему их уровень в крови может быть важным показателем здоровья.
СОВЕТ №2
Регулярно проходите медицинские обследования. Анализ крови может выявить наличие бластов и другие отклонения, что позволит своевременно диагностировать возможные заболевания, такие как лейкемия или другие расстройства крови.
СОВЕТ №3
Обсуждайте результаты анализов с врачом. Если в ваших анализах обнаружены бласты, важно получить профессиональную консультацию, чтобы понять, что это может означать для вашего здоровья и какие дальнейшие шаги следует предпринять.










